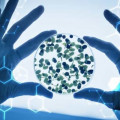

Լրահոս
 Աստղագուշակ՝ փետրվարի 28-ի համար
Աստղագուշակ՝ փետրվարի 28-ի համար
 Ջրի պակասը կարող է հանգեցնել միզապարկի հիվանդությունների
Ջրի պակասը կարող է հանգեցնել միզապարկի հիվանդությունների
 Կարծում եք՝ Ձեր հայրիկի՞ն եք նման. սխալվում եք. գենետիկայի մասին ամենահետաքրքիր փաստերը
Կարծում եք՝ Ձեր հայրիկի՞ն եք նման. սխալվում եք. գենետիկայի մասին ամենահետաքրքիր փաստերը
 Լիլիթ Հովհաննիսյանն ԱՄՆ-ից նոր լուսանկարներ է հրապարակել (ֆոտո)
Լիլիթ Հովհաննիսյանն ԱՄՆ-ից նոր լուսանկարներ է հրապարակել (ֆոտո)
 Ես ու Լիկան հանդիպում ենք. Աշոտ Սարգսյան
Ես ու Լիկան հանդիպում ենք. Աշոտ Սարգսյան
 Տեսնելով Մերի Մակարյանի այս լուսանկարը` արաբ շեյխը նրան կդարձներ իր 4-րդ կինը (լուսանկարներ)
Տեսնելով Մերի Մակարյանի այս լուսանկարը` արաբ շեյխը նրան կդարձներ իր 4-րդ կինը (լուսանկարներ)
 Իրինա Հարությունյանն արձագանքում է իր ու պայծառատես Անի Գրիգորյանի միջև սկանդալի լուրերին
Իրինա Հարությունյանն արձագանքում է իր ու պայծառատես Անի Գրիգորյանի միջև սկանդալի լուրերին
 Նուշը թույլ է տալիս նիհարել`առանց հատուկ սննդակարգի
Նուշը թույլ է տալիս նիհարել`առանց հատուկ սննդակարգի
 Կկարողանա՞ք արդյոք ճիշտ լուծել այս հանելուկը. հարկավոր է մի փոքր ուշադրություն
Կկարողանա՞ք արդյոք ճիշտ լուծել այս հանելուկը. հարկավոր է մի փոքր ուշադրություն
 Ինչպիսին է այսօր Վիպոյանի քարտուղարուհու դերակատար Արմինե Սուքիասյանը (Photo)
Ինչպիսին է այսօր Վիպոյանի քարտուղարուհու դերակատար Արմինե Սուքիասյանը (Photo)
 Շուշան Պետրոսյանին նվիրված «Բենեֆիս»-ը երգչուհուն նորովի է բացահայտում
Շուշան Պետրոսյանին նվիրված «Բենեֆիս»-ը երգչուհուն նորովի է բացահայտում
 Սիրուշոն հրապարակել է ավագ որդու լուսանկարը
Սիրուշոն հրապարակել է ավագ որդու լուսանկարը
 Մթերքներ, որոնք պաշտպանում են քաղցկեղից և կաթվածից (ֆոտոշարք)
Մթերքներ, որոնք պաշտպանում են քաղցկեղից և կաթվածից (ֆոտոշարք)
 «Կայարան» հեռուստասերիալի Արփին՝ իրական կյանքում
«Կայարան» հեռուստասերիալի Արփին՝ իրական կյանքում
 Բարսելոնայում բնակվող ֆոտոմոդել Աննա Բաբայանի 1 տարեկան դստեր տարեդարձը Մադրիդում
Բարսելոնայում բնակվող ֆոտոմոդել Աննա Բաբայանի 1 տարեկան դստեր տարեդարձը Մադրիդում
 Տեսեք, թե որքան է մեծացել փոքրիկ Նանուլիկը (Ֆոտո)
Տեսեք, թե որքան է մեծացել փոքրիկ Նանուլիկը (Ֆոտո)
 Ժեստերի լեզու. ինչպես հասկանալ, որ ձեզ խաբում են
Ժեստերի լեզու. ինչպես հասկանալ, որ ձեզ խաբում են
 Դերասան Գարիկ Սեպխանյանի ընտանեկան լուսանկարները
Դերասան Գարիկ Սեպխանյանի ընտանեկան լուսանկարները
 Որն է կենդանակերպի ամենացանկալի կին նշանը. տղամարդիկ պարզապես խենթանում են նրա համար
Որն է կենդանակերպի ամենացանկալի կին նշանը. տղամարդիկ պարզապես խենթանում են նրա համար
 Սյուզան Մարգարյանը անճանաչելիորեն փոխվել է (լուսանկար)
Սյուզան Մարգարյանը անճանաչելիորեն փոխվել է (լուսանկար)
 Վարունգի 10 օգտակար հատկանիշ, որոնց մասին քչերը գիտեն
Վարունգի 10 օգտակար հատկանիշ, որոնց մասին քչերը գիտեն
 Ինչը՞ կարող է ավելացնել տարիքային հիվանդությունների քանակը
Ինչը՞ կարող է ավելացնել տարիքային հիվանդությունների քանակը
 Գիտնականները հակաքաղցկեղային բնական նոր միջոց են հայտնաբերել
Գիտնականները հակաքաղցկեղային բնական նոր միջոց են հայտնաբերել
 Դիանա Մալենկոյի օրիգինալ ծնունդն ու նվիրական երազանքը
Դիանա Մալենկոյի օրիգինալ ծնունդն ու նվիրական երազանքը
 Աննա Դովլաթյանի 27-ամյակի խնջույքը՝ անակնկալ սիրելիից
Աննա Դովլաթյանի 27-ամյակի խնջույքը՝ անակնկալ սիրելիից
 Բոլորն ասում են դժվար է լինելու, բայց ես պատրաստ եմ. Նորա Գրիգորյան
Բոլորն ասում են դժվար է լինելու, բայց ես պատրաստ եմ. Նորա Գրիգորյան
 Կիվի`«սուպեր» միրգ
Կիվի`«սուպեր» միրգ
 Ո՞ր 2 մասնակիցները լքեցին հայկական X Factor նախագիծը
Ո՞ր 2 մասնակիցները լքեցին հայկական X Factor նախագիծը
 Այս խառնուրդն ընդունեք օրը 2 անգամ և առանց դժվարության նիհարեք
Այս խառնուրդն ընդունեք օրը 2 անգամ և առանց դժվարության նիհարեք
 «Իքս ֆակտոր» նախագիծը «փչացրեց» սիրված երգիչ Էրիկին
«Իքս ֆակտոր» նախագիծը «փչացրեց» սիրված երգիչ Էրիկին

 Երևանում բախվել են 3 մեքենա. կան վիրավորներ
Երևանում բախվել են 3 մեքենա. կան վիրավորներ
 Մոտ 2,5 միլիարդ դոլարի վնաս են կրելու գյուղմթերք արտադրողները․ Հրայր Կամենդատյան
Մոտ 2,5 միլիարդ դոլարի վնաս են կրելու գյուղմթերք արտադրողները․ Հրայր Կամենդատյան Հրապարակված են ընտրության մասնակիցների ստորագրված ցուցակները․ ստուգեք Ձեր հասցեները․ Գոհար Մելոյան
Հրապարակված են ընտրության մասնակիցների ստորագրված ցուցակները․ ստուգեք Ձեր հասցեները․ Գոհար Մելոյան Ռոնալդուն՝ 6 աշխարհի առաջնություններում գոլ խփած առաջին ֆուտբոլիստ (տեսանյութ)
Ռոնալդուն՝ 6 աշխարհի առաջնություններում գոլ խփած առաջին ֆուտբոլիստ (տեսանյութ)
 Հայտնի է Հայաստանի Մ-19 ԵԱ հավաքականի հանդիպումների ժամանակացույցը
Հայտնի է Հայաստանի Մ-19 ԵԱ հավաքականի հանդիպումների ժամանակացույցը
 Օդի ջերմաստիճանը կնվազի․ եղանակն՝ առաջիկա օրերին
Օդի ջերմաստիճանը կնվազի․ եղանակն՝ առաջիկա օրերին
 Երևանում մեքենաներ են բախվել․ վիրավորներ կան
Երևանում մեքենաներ են բախվել․ վիրավորներ կան
 Ուղևորի մեքենան վնասել են «Զվարթնոց»-ի վճարովի կայանատեղիում․ օդանավակայանը խուսափում է պատասխանատվությունից
Ուղևորի մեքենան վնասել են «Զվարթնոց»-ի վճարովի կայանատեղիում․ օդանավակայանը խուսափում է պատասխանատվությունից
 Ռուսաստանի և ՆԱՏՕ-ի միջև ուղիղ ռազմական բախման վտանգն աճում է․ դիվանագետ
Ռուսաստանի և ՆԱՏՕ-ի միջև ուղիղ ռազմական բախման վտանգն աճում է․ դիվանագետ
 Վրաստանում երկրաշարժ է տեղի ունեցել
Վրաստանում երկրաշարժ է տեղի ունեցել
 Շախմատի պատանեկան ԱԱ. Վաչե Հովակիմյանը լավագույն եռյակում է 7 խաղափուլից հետո
Շախմատի պատանեկան ԱԱ. Վաչե Հովակիմյանը լավագույն եռյակում է 7 խաղափուլից հետո
 ԵԱՏՄ-ում հուլիսի 1-ից ուժի մեջ կմտնեն էլեկտրոնային առևտրի նոր կանոնները
ԵԱՏՄ-ում հուլիսի 1-ից ուժի մեջ կմտնեն էլեկտրոնային առևտրի նոր կանոնները
 Ռուսական հացահատիկի հերթական խմբաքանակը Հայաստան է ուղարկվել Ադրբեջանի տարածքով
Ռուսական հացահատիկի հերթական խմբաքանակը Հայաստան է ուղարկվել Ադրբեջանի տարածքով
 Հայաստանը Բրյուսելում ստորագրել է ՀՀ սահմանային անցակետերի ուսումնասիրության վերաբերյալ փաստաթղթեր
Հայաստանը Բրյուսելում ստորագրել է ՀՀ սահմանային անցակետերի ուսումնասիրության վերաբերյալ փաստաթղթեր
 Վանաձոր-Սպիտակ ճանապարհին մեքենաներ են բախվել․ վիրավորներ կան
Վանաձոր-Սպիտակ ճանապարհին մեքենաներ են բախվել․ վիրավորներ կան
 Ջուր հավաքեք. ջուր չի լինելու
Ջուր հավաքեք. ջուր չի լինելու
 Grundfos Tech Day․ Երևանում ներկայացվեց ջրամատակարարման «ոսկե ստանդարտը» (տեսանյութ)
Grundfos Tech Day․ Երևանում ներկայացվեց ջրամատակարարման «ոսկե ստանդարտը» (տեսանյութ)
 Վրաերթ՝ Երևանում․ 23-ամյա վարորդը «Mercedes»-ով վրաերթի է ենթարկել փողոցը թույլատրելի հատվածով հատող 2 հետիոտների․ վերջինները տեղափոխվել են հիվանդանոց
Վրաերթ՝ Երևանում․ 23-ամյա վարորդը «Mercedes»-ով վրաերթի է ենթարկել փողոցը թույլատրելի հատվածով հատող 2 հետիոտների․ վերջինները տեղափոխվել են հիվանդանոց
 Լիտվայի կառավարությունը հրաժարական է տվել
Լիտվայի կառավարությունը հրաժարական է տվել
 Պուտինը հայտարարել է՝ Արևմուտքը մեծ ծավալներով ԱԹՍ-ներ է մատակարարում Ուկրաինային
Պուտինը հայտարարել է՝ Արևմուտքը մեծ ծավալներով ԱԹՍ-ներ է մատակարարում Ուկրաինային
 Արտակարգ դեպք՝ Արմավիրի մարզում․ Դալարիկ գյուղում բախվել են բեռնատար գնացքն ու դիզվառելիք տեղափոխող «ԿամԱԶ»-ը․ վերջինը կոտրել է բետոնե սյունն ու կողաշրջվել․ կա վիրավոր
Արտակարգ դեպք՝ Արմավիրի մարզում․ Դալարիկ գյուղում բախվել են բեռնատար գնացքն ու դիզվառելիք տեղափոխող «ԿամԱԶ»-ը․ վերջինը կոտրել է բետոնե սյունն ու կողաշրջվել․ կա վիրավոր
 Իմ հոդվածը՝ հրապարակված գերմանական հեղինակավոր Berliner Zeitung պարբերականում․ Արթուր Միքայելյան
Իմ հոդվածը՝ հրապարակված գերմանական հեղինակավոր Berliner Zeitung պարբերականում․ Արթուր Միքայելյան «Ուժեղ Հայաստանը» պատրաստվում է վիճարկել ընտրությունների արդյունքները Սահմանադրական դատարանում
«Ուժեղ Հայաստանը» պատրաստվում է վիճարկել ընտրությունների արդյունքները Սահմանադրական դատարանում Քննարկվել են Հայաստանի ու Իրանի սահմանային թողունակության աճին միտված հարցեր
Քննարկվել են Հայաստանի ու Իրանի սահմանային թողունակության աճին միտված հարցեր
 Զավեշտ է ու ողբերգություն. հիմա էլ ուրիշ բանի համար են երդվում. Արթուր Զաքարյան
Զավեշտ է ու ողբերգություն. հիմա էլ ուրիշ բանի համար են երդվում. Արթուր Զաքարյան Իրանի ամբողջ տարածքում վերականգնվել է օդային երթևեկությունը
Իրանի ամբողջ տարածքում վերականգնվել է օդային երթևեկությունը
 «Ford»-ը Մյասնիկյան պողոտայում բախվել է ծառին․ կան վիրավորներ
«Ford»-ը Մյասնիկյան պողոտայում բախվել է ծառին․ կան վիրավորներ
 Անցած 1 օրում գրանցվել է 10 ավտովթար․ 1 մարդ զոհվել է, 25-ը՝ վիրավորվել
Անցած 1 օրում գրանցվել է 10 ավտովթար․ 1 մարդ զոհվել է, 25-ը՝ վիրավորվել
 Պատերազմը, միևնույն է՛ մի օր լինելու է, որովհետև կզած երկրին մզում են մինչև վերջ. Արշակ Կարապետյան
Պատերազմը, միևնույն է՛ մի օր լինելու է, որովհետև կզած երկրին մզում են մինչև վերջ. Արշակ Կարապետյան Հրապարակվել է պատգամավորական երդման նոր տեքստը
Հրապարակվել է պատգամավորական երդման նոր տեքստը
 Մբապե. Մեսին միշտ է գոլ խփում, ես դրա վրա չեմ կենտրոնանում
Մբապե. Մեսին միշտ է գոլ խփում, ես դրա վրա չեմ կենտրոնանում
 Վերականգնվում է Երևան-Սևան ճանապարհի վրա կայծակի հարվածից վնասված կամուրջը (տեսանյութ)
Վերականգնվում է Երևան-Սևան ճանապարհի վրա կայծակի հարվածից վնասված կամուրջը (տեսանյութ)
 Մինչ ձեզ կերակրում են «խաղաղության» վարդագույն պատրանքներով, ԱՄՆ Կոնգրեսում Ադրբեջանը հակահայ համաժողով է կազմակերպում․ Մարիաննա Ղահրամանյան
Մինչ ձեզ կերակրում են «խաղաղության» վարդագույն պատրանքներով, ԱՄՆ Կոնգրեսում Ադրբեջանը հակահայ համաժողով է կազմակերպում․ Մարիաննա Ղահրամանյան Հայաստանը կներկայացնի կլիմայական օրակարգը Լոնդոնում անցկացվող միջազգային համաժողովում
Հայաստանը կներկայացնի կլիմայական օրակարգը Լոնդոնում անցկացվող միջազգային համաժողովում
 Մեր ազգին հաղթել չի լինի, եթե ազգը լինի միաբան. Համահայկական Ճակատ
Մեր ազգին հաղթել չի լինի, եթե ազգը լինի միաբան. Համահայկական Ճակատ Ոստիկանները հայտնաբերել են անհետ կորած տղամարդու մարմինը
Ոստիկանները հայտնաբերել են անհետ կորած տղամարդու մարմինը
 Զավեշտ է ու ողբերգություն. Հիմա էլ ուրիշ բանի համար են երդվում. Արտակ Զաքարյան
Զավեշտ է ու ողբերգություն. Հիմա էլ ուրիշ բանի համար են երդվում. Արտակ Զաքարյան Ապօրինի պահվող զենք-զինամթերքի կամավոր հանձնման դեպքերը շարունակվում են. ոստիկանությունը ներկայացրել է արդյունքները (տեսանյութ)
Ապօրինի պահվող զենք-զինամթերքի կամավոր հանձնման դեպքերը շարունակվում են. ոստիկանությունը ներկայացրել է արդյունքները (տեսանյութ)
 Հայաստան Ադրբեջանով հացահատիկ կուղարկվի
Հայաստան Ադրբեջանով հացահատիկ կուղարկվի
 Այն ինչ կատարվեց Երևանի ավագանու նիստին, որքան էլ սարսափելի է, բայց շատ օրինաչափ է․ Գոհար Ղումաշյան
Այն ինչ կատարվեց Երևանի ավագանու նիստին, որքան էլ սարսափելի է, բայց շատ օրինաչափ է․ Գոհար Ղումաշյան ԿԸՀ-ի որոշումը հակասահմանադրական և հակաօրինական է․ Արմեն Մանվելյան
ԿԸՀ-ի որոշումը հակասահմանադրական և հակաօրինական է․ Արմեն Մանվելյան Ի պատասխան Սյունիքի դարպասները թշնամու առջև բացած փոքրիկ խմբակի. Անուշ Միրզոյան
Ի պատասխան Սյունիքի դարպասները թշնամու առջև բացած փոքրիկ խմբակի. Անուշ Միրզոյան Հուլիսի 1-ից շուրջ 166.000 քաղաքացիներ զրկվելու են իրենց նպաստներից․ Հրայր Կամենդատյան
Հուլիսի 1-ից շուրջ 166.000 քաղաքացիներ զրկվելու են իրենց նպաստներից․ Հրայր Կամենդատյան Ընտրակաշառք բաժանողն իշխանությունն էր, ոչ թե ընդդիմությունը․ Մենուա Սողոմոնյան
Ընտրակաշառք բաժանողն իշխանությունն էր, ոչ թե ընդդիմությունը․ Մենուա Սողոմոնյան Հայաստանի կառավարությունը հրաժարվում է անցյալից, Ադրբեջանի կառավարությունը հնարում է նոր անցյալ. Նարեկ Կարապետյան
Հայաստանի կառավարությունը հրաժարվում է անցյալից, Ադրբեջանի կառավարությունը հնարում է նոր անցյալ. Նարեկ Կարապետյան
 Ֆոն դեր Լայենը ծրագրում է այցելել Հայաստան. Politico
Ֆոն դեր Լայենը ծրագրում է այցելել Հայաստան. Politico
 Յունիբանկը և Unisport ակումբը մասնակցել են «Tricolor» Yerevan Beat Run վազքին
Յունիբանկը և Unisport ակումբը մասնակցել են «Tricolor» Yerevan Beat Run վազքին
 Նոր փոփոխություն բանակի հետ կապված
Նոր փոփոխություն բանակի հետ կապված Ռուս-հայկական համալսարանը փոխել է պաշտոնական անվանումը
Ռուս-հայկական համալսարանը փոխել է պաշտոնական անվանումը
Երեկ Հորմուզի նեղուցով անցել է 19 միլիոն բարել նավթ. Թրամփ
Երեկ Հորմուզի նեղուցով անցել է 19 միլիոն բարել նավթ. Թրամփ


1
Անտառում հայտնաբերել են դպրոցական աղջկա կիսամերկ մարմինը
2
Հերթական անոմալ չափերի օձը Հայաստանում
3
Աղբամանում նորածին երեխա է հայտնաբերվել
4
Տեսախցիկը ֆիքսել է Արմավիր-Բաղրամյան ավտոճանապարհին 31-ամյա մոդել Վերա Սաֆարյանի կյшնքը խլшծ шվտnվթш...
5
Վթարային ջրանջատում. ո՞ր հասցեներում ջուր չի լինի՝ հունիսի 21-ին




